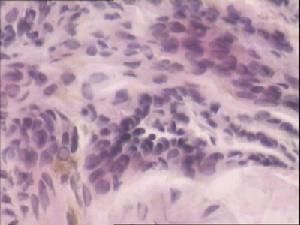
外陰黑色素瘤 外陰黑色素瘤

原因
外陰黑色素瘤(一)發病原因
外陰惡性黑色素瘤常來源於結合痣或複合痣。儘管有一些外陰惡性黑色素瘤家族史的報導,但有關家族性外陰黑色素瘤的材料幾乎缺如,有皮膚黑色素瘤家族史者患外陰惡性黑色素瘤的年齡早於無家族史者,二者相對應的年齡為44.8歲和49.7歲。有家族史者可能有多發病灶和良好預後傾向。與妊娠有關的證據存在有懷疑,尚未定論。其他因素如性夥伴、激素影響等也未顯示出與外陰黑色素瘤發病有關。
(二)發病機制
1.黑色素瘤的臨床病理生長形式 按照色素瘤的生長發展方式,一般皮膚黑色素瘤可分為3種類型:淺表蔓延型、結節型和雀斑型。
(1)淺表蔓延型:尖銳,邊緣呈弧形,表面隆起不平,可出現結節。外觀呈雜色,有褐、棕、灰、黑、粉紅和白色混合組成。在侵犯基質以前有一個範圍相對較大放射狀生長階段,一旦進入向基質垂直生長浸潤階段,臨床疾病進展相當快。淺表蔓延型約占皮膚黑色素瘤的70%,1/2~2/3的外陰黑色素瘤表現為淺表蔓延型生長。
(2)結節型:有黑色和藍黑色兩種,表面光滑或不平。此型僅存在垂直浸潤生長階段,病史短暫,在診斷時具有較深的基質浸潤。此型占皮膚黑色素瘤的10%~15%,占外陰黑色素瘤的25%~50%。
(3)雀斑型:復蓋面積大而邊沿不齊,顏色為深淺程度不同的棕色,其特點為放射狀生長,向深部浸潤發展,確診時一般屬晚期。該型占外陰黑色素瘤的0%~10%。
2.外陰黑色素瘤的大體觀 常見於無毛髮分布區,65%~70%起自於或累及外陰的黏膜面,25%僅累及一側大陰唇,10%累及陰蒂,約有20%的患者就診時呈廣泛病變。臨床經常可見到局部皮膚或黏膜呈藍黑色、黑褐色或無色素不等,病變界限不清,病灶為扁平、凸起或息肉狀,可有潰瘍、腫脹或皮膚衛星狀轉移結節形成等改變。病變範圍小者數毫米,大者十幾厘米。10%的黑色素瘤為無色素的黑色素瘤。
3.外陰黑色素瘤的光鏡下特點 黑色素瘤由上皮細胞、痣細胞和梭狀細胞組成,這3種細胞的黑色素程度不同。組織形態變化很大,可類似於上皮或間葉來源的腫瘤,也可類似於未分化癌。細胞大小差異明顯,呈圓形、多角形、梭形或多形性。核異型性明顯,亦可見多核或巨核細胞。常有明顯的核仁,核分裂象多見。瘤細胞多呈巢狀或瀰漫分布,少數淺表型瘤細胞僅在表皮內浸潤。
4.外陰黑色素瘤與外陰黑色素痣的關係 10%外陰黑色素瘤是由外陰痣惡變而來。先前存在痣(preexisting nevi)被認為是黑色素瘤的前體,Rafnarsson-olding報導5.5%外陰黑色素瘤合併有先前存在黑痣,均生長在陰唇有毛髮的皮膚部位,71%與淺表蔓延型生長方式有關,生長在有毛髮陰唇皮膚的5例淺表型生長的黑色素瘤均合併有先前存在痣。鏡下可見良性的皮膚痣、惡性黑色素瘤及不典型的痣細胞相鄰共存,顯示出從良性到惡性黑色素瘤的轉化過渡過程。作者認為在外陰光滑皮膚部位的黑色素瘤屬於新生黑色素瘤。生長在陰唇有毛髮部位的淺表型生長的黑色素瘤與其他部位的皮膚黑色素瘤一樣,最有可能是來自於外陰黑色素痣的惡變。
外陰黑色素瘤有哪些表現及如何診斷?
外陰黑色素瘤的症狀類似於其他外陰惡性腫瘤。儘管外陰黑色素瘤可無症狀偶然體檢時發現,但其最常見的主訴是外陰腫塊。其次為外陰出血或瘙癢,外陰潰瘍、排尿困難、疼痛,頭痛和體重減輕不太常見,這些症狀往往出現於較晚期的患者。若疾病的晚期腹股溝部位由於腫瘤的轉移可出現腫脹。一些合併有先前存在痣的患者痣增大等改變。Rafnarsson-Olding報導198例外陰黑色素瘤,34.8%者出現外陰出血症狀,28.3%有外陰包塊史,15.2%和13.6%患者分別感到外陰的瘙癢和燒灼刺激感,排尿不適和陰道排液分別占12.1%和10.6%,潰瘍、疼痛、局部變黑等症狀出現比率不超過5%。
分期
外陰黑色素瘤1.臨床分期 最早和最簡單的分期系統。I期:腫瘤局限於外陰,有或不伴有距原發灶2cm內的衛星灶。Ⅱ期:腫瘤播散到區域淋巴結,也包括距原發腫瘤轉移2cm以上,位於原病灶區域淋巴引流以內的皮膚或皮下結節。Ⅲ期:腫瘤轉移超過區域淋巴結範圍。
2.FIGO分期和TNM分期 見表1。
3.顯微分期 1969年Clark按惡性黑色素瘤對真皮乳頭層、網狀層及皮下脂肪層的侵犯程度、所涉及患者的預後不同,提出5個侵犯等級。1970年Breslow提出腫瘤厚度(浸潤最深的截面上測量)與腫瘤最長徑的乘積來估計預後,同樣將黑色素瘤分為5個等級,也就是說clark按皮膚的解剖標記而Breslow按腫瘤的侵犯厚度進行分級。但由於外陰陰唇部位的皮膚缺乏定義明確的真皮乳頭,Chung等又提出了Breslow改良分級。Clark分級、Breslow分級及chung分級系統見表2。
4.美國癌症聯合會(AJCC)分期 見表3。
外陰黑色素瘤1.臨床表現 根據黑色素瘤的病史、症狀和體徵,初步獲得外陰黑色素瘤的診斷並不困難。
2.組織學診斷依據 組織病理學診斷對黑色素瘤是必須具備的,術前可通過簡單病灶直接塗片細胞學檢查的方法行初步篩查,協助早期診斷。小的皮膚病損應呈圓周形地切除病灶,注意切除的邊緣應距周圍正常皮膚0.5~3cm,並帶有部分皮膚下的組織,以便於確定病損的整個厚度。對於大的病損,套用Keys打孔器(Keys puncb)可獲得一全層厚度的活檢標本。行活檢或活切術時應作好根治術的準備,獲得的標本立即快速冰凍病檢。對任何外陰色素沉著性病變禁忌任意做局部的活切,導致腫瘤的人為擴散和促使腫瘤轉移。
3.免疫組織化學染色 根據惡性黑色素瘤的皮膚病損不規則、細胞形態及組織結構多樣性、細胞與細胞間見粉末狀黑色素顆粒等特徵,該病的診斷並不難。對於極少色素性黑色素瘤,必須與分化差的鱗狀細胞癌、腺癌及纖維肉瘤等相鑑別。
4.電鏡觀察和組織培養 對HMB-45陰性的極少色素性黑色素瘤行電鏡觀察,在腫瘤細胞中有前黑素小體及一些黑色素瘤的超微結構特點,以便於診斷和鑑別診斷。無色素的黑色素瘤也可行組織培養產生黑色素。
檢查
外陰黑色素瘤1.免疫組織化學染色 黑色素瘤細胞Keratin、Vimentin、S-100、HMB-45等抗原的聯合組化染色有助於黑色素瘤的診斷和鑑別診斷。一般Keratin呈陰性染色,Vimentin及S-100全部陽性反應。HMB-45為惡性黑色素瘤的特異性抗體,但有些惡性黑色素瘤不表達色素抗原,文獻報導HMB-45在惡性黑色素瘤中表達率為90.6%。
2.組織培養 無色素的黑色素瘤也可行組織培養產生黑色素。
組織病理學檢查 單克隆抗體HMB-45對黑色素瘤有高度敏感性及特異性,以此進行免疫組化染色,可輔助病理診斷。在切除活體組織時應包括一些邊緣的正常組織。
診斷
早期診斷則將明顯改善預後,特別是表淺擴散型及惡性雀斑型,本病早期徵象可歸納為4點,即ABCD徵象。
A(asymmetry):不對稱病變。
B(borderirregularity):邊緣不規則。
C(colorvariegation):顏色多樣。
D(diameterenlarging):直徑擴大。
注意這4點往往可以得到較早的診斷。對任何外陰色素性疾病都應引起高度警惕,特別是呈結節型的或色素加深的都應迅速取得組織學的診斷。一般應將整個色素區域並包括周邊正常皮膚2~3mm一併切除活檢。對於較大的病灶,也可在住院手術準備下行楔形活檢或點式活檢,活檢應注意組織深度以利分期。
保守治療
生物反應調節劑(biologicalresponsemodifiers,BRM)又名生物調節劑,是免疫治療劑的新術語。凡某一類物質主要通過免疫系統直接或間接增強機體的抗腫瘤效應,並對腫瘤有治療效果的藥劑或方法,都可稱為生物反應調節劑。
這些BRM藥物包括對機體免疫功能有增強作用、調節作用及能恢復、重建免疫功能的藥物,多種細胞因子如淋巴因子、單核因子、腫瘤生長抑制因子和胸腺因子等;免疫活性細胞如細胞毒性T淋巴細胞、淋巴因子激活的殺傷細胞,細胞因子激活的腫瘤浸潤淋巴細胞等。
另外,某些中藥、多糖類,皂苷類及微量元素也能促進免疫功能,均可以作為生物調節劑。國家批准的皂苷類BRM藥物其中效果突出的是人參皂苷rh2。其主成分是從人參中提取出來的一種抗癌的活性小分子,能阻斷癌細胞DNA,抑制癌細胞增殖,誘導癌細胞分化,控制腫瘤的活動。而且對體質虛弱的病人有更明顯的效果,可提升抗病能力,提升生活質量。同時,基本無毒副作用,可作為其他治療的最佳的藥物選擇
疾病鑑別
外陰色素沉著性皮膚病損非常常見,常不被病人注意,通常這些病損屬良性病變,容易與外陰黑色素瘤相混淆,需要與這些常見的病損相鑑別。外陰常見的良性色素沉著病損有單純性著色斑、外陰的黑變病、各種痣、黑棘皮症、脂溢性角化病。外陰惡性腫瘤如上皮內瘤變、鱗癌、基底細胞癌、外陰Paget病等也具有色素沉著改變的特點。由於黑色素瘤組織結構表現的多樣性,光鏡下黑色素瘤細胞中的上皮樣細胞須與鱗癌和腺癌相鑑別,梭形細胞需與平滑肌肉瘤相區別,有時還需與惡性中胚葉(包括絨癌)相區別,尋找細胞及組織內的色素顆粒對診斷有幫助。
1.外陰皮膚痣 痣生長緩慢,局部病損穩定,表面高出皮膚,光鏡下可以區別二者。若痣出現色素沉著範圍擴大、色素加深、表面有潰瘍出血,尤其是外陰有毛髮的皮膚部位的痣,應高度懷疑是痣的惡變。
2.尿道肉阜 尿道口周圍的黑色素瘤易誤診為尿道肉阜,肉阜淡紅色或深紅色,邊界清,表面光滑,生長慢,質軟,無明顯的色素沉著,仔細體檢結合病理改變容易鑑別。
3.外陰基底細胞癌 多見於老年婦女,好發在大陰唇前部,腫瘤生長緩慢,常伴有出血及潰瘍形成,腫瘤硬,邊界清,表面粗糙呈顆粒狀,可為黑色,色素沉著一般在病灶的周圍,須與黑色素瘤鑑別,鏡下可以鑑別二者。
4.外陰Paget病 多發生在絕經後婦女,病變多位於大陰唇和肛周,大小不等,呈濕疹樣變化,可形成淺潰瘍和結痂,邊界清。鏡下有Paget細胞浸潤,也可見吞噬黑色素的細胞。常與淺表型的黑色素瘤相混淆,通過免疫組化染色鑑別二者。
食療
外陰黑色素瘤食療方(下面資料僅供參考,詳細需要諮詢醫生)
1.人參粥 以人參末3g(或黨參15g),冰糖適量,好米100g,煮粥常食。
2.黃芪粥 黃芪50g,煎水取汁以作煮粥水,好米100g,紅糖適量,陂皮末3g,共煮粥。
3.歸芪蒸雞 當歸20g,黃芪100g,母雞1隻,共蒸熟後分次服用。
4.參棗米飯:人參3g(或黨參15g),大棗20g,好米250g,白糖50g。參、棗切碎與共蒸,米熟飯成,加白糖分次服用。
5.術棗餅 白朮30g,大棗250g,雞內金、乾薑、麵粉、油、鹽等調料適量。諸藥研末或切極細,與麵粉、調料合勻,煎餅,分次食用。
惡性黑色素瘤患者,還常見有腎虧表現,針對肝腎不足,可選用以下飲食:
1.蟲草枸杞 冬蟲夏草10g,枸杞子20g,瘦豬肉100g,雞蛋250g,調料適量,燉熟後分次服用。
2.枸杞粥 枸杞子30g,好米100g,共煮粥。
3.核桃鴨 核桃仁200g,雞肉100g,荸薺150g,老鴨1隻,料灑少許,油鹽適量,共燉熟,分次服用。
針對惡性黑色素瘤患者的毒瘀之象,可選用以下飲食:
1.大蒜粥 紫皮大蒜30g,好米100g,共煮粥。
2.蘆筍香菇湯 蘆筍200g,香菇100g,文火熬湯,可加適量調料飲食。
3.菱粉粥 菱角粉60g,好米100g,共煮粥。
外陰黑色素瘤吃那些對身體好?
(1)術後耗氣傷血,宜多食補氣養血之品,如大棗、龍眼、扁豆、粳米、荔枝、香菇、胡蘿蔔、鵪鶉蛋、藕粉、豆類等。
(2)放療時耗陰損液,宜多食滋陰養液之品,如菠菜、小百菜、藕、犁、西瓜、香蕉、葡萄、海參、甘蔗、百合等。
(3)化療易氣血兩損,宜常食補養氣血之物,如木耳、香菇、核桃仁、桑椹、苡米粥、紅棗、桂圓、海參等。
(4)多吃富含維生素A、維生素C的飲食,多吃綠色蔬菜和水果。
(5)常吃含有抑制致癌作用的食物,如苤藍、捲心菜、薺菜等。
(6多吃精米、全麥片、王谷雜糖、玉米面、黃米飯、豆類(黃豆、扁豆、架豆、豌豆)等。
(7)常吃富有營養的乾果種子類食物,如葵花子、芝麻、南瓜子、花生、葡萄乾、等。這些食物含多種維生素、礦物制裁及纖維素、蛋白質和非飽合脂肪酸等。
外陰黑色素瘤最好不要吃那些食物?
(1)少吃精米、精面,不吃鹽醃及煙燻的食物,特別是烤糊焦化了的食物。
(2)堅持低脂肪飲食,常吃些瘦肉、雞蛋及優酪乳。
(3)食物應儘量保持新鮮,不吃發霉變質的飲食。
(4)保持大便通暢,便秘病人應吃富含纖維素的食品及每天喝一些蜂蜜。
(5)忌咖啡等興奮性飲料。
(6)忌蔥、蒜、姜、桂皮等辛辣刺激性食物。
(7忌公雞、豬頭肉等發物。
(7)忌海鮮。
(8)忌羊肉、狗肉、韭菜、胡椒等溫熱性食物。
(9)忌煙、酒。
預防
一.女性患者有外陰瘙癢、出血,色素沉著範圍增大、外陰黑痣時,應及早治療、做好隨訪。
二. 預後:
1.一般預後判斷 外陰黑色素瘤的復發率為51%~93%,最常見的復發部位為外陰、陰道,其次為腹股溝。37%~40%出現遠處轉移,最常見的轉移部位為肺、骨、肝、腦。復發患者,29%出現多發病灶。復發的平均時間為1年,患者多死於遠處轉移。疾病出現復發後預後差,平均生存5.9個月,5%的5年生存率。
外陰黑色素瘤的5年生存率為8%~56%,平均為36%,10年生存率為37%。國內文獻報導的5年生存率為20%。Figge等發現20%外陰黑色素瘤復發患者的復發時間是在5年或5年後,這部分復發患者無一例長期生存,這樣外陰黑色素瘤患者長期存活率要比5年生存率低得多,可能對外陰黑色素瘤的5年生存率易造成誤解,因此對生存超過5年以上的患者仍應隨訪,及時發現和治療復發。
與外陰黑色素瘤預後有關的因素有腫瘤侵犯的深度、表面潰瘍形成、細胞類型、腫瘤生長方式、腫瘤部位、有絲分裂率、炎症反應、淋巴-血管表面受累、腫瘤的大小、DNA倍體、年齡、淋巴結轉移、FIGO分期和AJCC分期。
(1)年齡與預後:年齡是外陰黑色素瘤患者生存有意義的獨立預後因素,年齡大者預後差,年齡對生存影響的危險係數是每10年1.4。Gog的前瞻性研究發現老年患者將顯著增加疾病復發的危險性,每10年將有一個26%的增加率。平均年齡為67歲以上的患者腫瘤易出現血管的浸潤、表面潰瘍、染色體非整倍體及腫瘤厚度>5mm。
(2)病變部位與預後:中心部位的腫瘤預後顯著差於兩側部位。中心部位的原發腫瘤與旁側腫瘤相比有著較高的淋巴結受累危險性和復發危險性。患側旁部位腫瘤病人的生存時間顯著長於陰蒂部位或多發病灶者。
(3)生長方式和細胞類型與預後:預後逐漸變壞的生長方式順序為淺表蔓延型、混合型、雀斑型、結節型、未分類型。預後逐漸變壞的細胞類型為索型、上皮型、混合型、多形性型。
(4)有絲分裂率與預後:有絲分裂率越高生存期短。
(5)淋巴-血管表面受侵與預後:有淋巴血管受侵者生存率降低。
(6)腫瘤大小與預後 腫瘤直徑>2cm者預後差於<2cm者。
(7)淋巴結轉移與預後:淋巴結轉移者生存率明顯降低。Scheistroen報導有淋巴結轉移者5年生存率為0,無轉移者為56%。淋巴結轉移與腫瘤的血管表面受侵、表面潰瘍形成、非整倍體、厚度>5mm、年齡>67歲有關。
(8)FIGO分期和AJCC分期與預後:FIGOI、Ⅱ期患者預後顯著好與Ⅲ、Ⅳ期。Scheistroen報導Ⅰ、Ⅱ、Ⅲ、Ⅳ的5年生存率分別為63.2%,44.2%,0,0;10年生存率分別為51.6%,35.4%,0,0。GOG前瞻性研究報導,AJCCI期患者的5年生存率為85%,Ⅱ期為40%,Ⅲ期為25%,認為AJCC分期系統與疾病的復發時間有關,AJCC分期系統對疾病結局的預測較FIG0分期準確,AJCC分期可以決定預後和選擇治療,建議外陰黑色素瘤採用AJCC的分期。最近Verschraegen報導51例外陰黑色素瘤,AJCC分期Ⅰ期占29%,Ⅱ期占50%,Ⅲ期占16%,Ⅳ占7%,Ⅰ期的5年生存率為91%,≥ⅡA者為31%(P=0.0002),AJCC分期是與患者總生存和無瘤生存有關的主要預後指標,分別為P=0.0001和P≤0.0001。
(9)腫瘤表面潰瘍形成與預後:潰瘍形成代表腫瘤進展迅速,是疾病無瘤生存、長期生存和復發的重要預後指標。有潰瘍形成者的5年生存率為14.3%~40.5%,無潰瘍形成者5年生存率為20%~62.7%。
(10)腫瘤厚度和浸潤深度:Chung和Clark分級代表著腫瘤的浸潤程度,Breslow分級代表腫瘤的厚度,多位學者的臨床研究都不同程度地證明這3種顯微分期系統都與腫瘤的預後有關。Chung和Breslow分級較Clark分級對疾病的預後預測準確。Trimble套用Chung和Breslow顯微分級系統分析了65例外陰黑色素瘤患者,符合Chung分期的有47例,其中Chung Ⅰ期1例,Ⅱ期12例,Ⅲ期8例,Ⅳ期20例,V期6例,各期的5生存率分別為100%、81%、87%、4%、17%,各期的10年生存率分別為100%、81%、87%、11%、33%。符合Breslow分期的有65例,Ⅰ期12例、Ⅱ期10例、Ⅲ期和Ⅳ期共9例、V期34例,相對應5年的生存率分別為48%,79%,56%,44%。因此,作者認為Chung顯微分期系統較Breslow系統能更好反應外陰黑色素瘤生存、淋巴結轉移和結局。GOG認為AJCC系統是最好的反應外陰黑色素瘤結局的系統,在缺乏ACJJ分期系統的情況下Breslow分級將是最好的分級系統。
2.黑色素瘤的部分分子生物學研究對預後的判斷 流式細胞儀染色體倍體檢測:皮膚惡性黑色素瘤的DNA流式細胞儀檢測顯示非染色體整倍體是疾病預後較差的指標。Scheistroen等套用流式細胞儀對75例黑色素瘤石蠟包埋的組織行染色體倍體檢測,發現二倍體、四倍體、非整倍體及不能評價的患者5年生存率分別為60.9%,44.4%,32.5%,71.4%;10年生存率分別為60.9%,44.4%,23.2%、42.0%,染色體倍體之間的生存率統計有顯著差異(P=0.0101)。多因素分析顯示,在初治手術的患者DNA倍體是疾病無瘤和長期生存的獨立預後因素。在與疾病無瘤生存的預後指標中,DNA倍體的預測次於血管的浸潤和就診時的年齡,在預測疾病的長期生存方面,DNA倍體僅次於腫瘤生長的位置。整倍體腫瘤預後最好,非整倍體腫瘤有著較大的復發危險性和較壞的預後。
治療前注意事項
預防
1、對於一名女性而言,最簡單的檢查方法是洗浴時的自我檢查,對於已婚育女性應作定期婦科檢查,這樣就能及時地發現婦科、甚至是其他婦科疾病。一旦發現外陰色素痣增大、隆起、出血、潰瘍及瘙癢等症狀,均應及時到醫院就診,儘量做到早期診斷、早期治療。
2、應注意個人衛生,保持外陰清潔。在穿著方面,應選用對外陰皮膚刺激較小的全棉內褲,以及寬鬆、柔軟、透氣的外褲,以減少對外陰皮膚的摩擦。
3、對可疑病人要明確診斷,注意切勿進行病灶局部活檢,而應在作好手術切除的準備下,將病灶完整切除,其切緣應距離病灶2-3厘米以上,切除的標本進行快速冰凍切片檢查,如確診為惡性黑色素瘤,即進一步作擴大手術。
外陰黑色素瘤中醫治療方法
1、中成藥均為口服。
(1)西黃丸 清熱解毒,化痰散結,活血止痛。主治痰瘀內結,疼痛較劇者。每丸3g,每次1丸,每日2次。
(2)小金丸 6g,每日2次。適用於痰瘀內結型。
(3)大黃庶蟲丸 每次1丸,每日2次。適用於氣滯血瘀型。
(4)六味地黃丸 每次20粒,每日2次。適用於肝腎陰虛型。
(5)附子理中丸 每次1丸,每日2次。適用於脾腎陽虛型。
2、手術後飲食調養:
(1)耗氣傷血,宜多食補氣養血之品,如大棗、龍眼、扁豆、粳米、荔枝、香菇、胡蘿蔔、鵪鶉蛋、藕粉、豆類等。
(2)放療時耗陰損液,宜多食滋陰養液之品,如菠菜、小百菜、藕、犁、西瓜、香蕉、葡萄、海參、甘蔗、百合等。
(3)化療易氣血兩損,宜常食補養氣血之物,如木耳、香菇、核桃仁、桑椹、苡米粥、紅棗、桂圓、海參等。
外陰黑色素瘤西醫治療方法
1.外陰色素沉著性病變處理 不必去除所有外陰色素沉著性病變,尤其是良性痣,但臨床懷疑有惡變或惡性腫瘤存在時活檢是有必要的。所有先天性痣、交界性痣及不典型增生痣應該切除。直徑>5mm,邊界不規則、不清晰,帶有斑點樣的色素沉著的病變應考慮切除。另外,色素沉著病變增大、色素加深、產生刺激症狀或出現潰瘍出血者應切除。有家族史或黑色素瘤史和(或)其他類似病史的不典型痣應在皮膚癌專家的嚴密監護之下隨訪。
2.手術治療
(1)手術方式:外陰黑色素瘤的處理是一種平衡,既達到局部疾病控制又減少治癒率,並不是手術範圍越大越好。傳統的治療外陰黑色素瘤的標準方法與外陰鱗癌的治療類似,即實施外陰根治性手術加雙側腹股溝淋巴結和盆淋巴切除術。隨著外陰鱗癌治療傾向於個體化和手術範圍的縮小及其他部位皮膚黑色素瘤的治療變的更加保守,外陰黑色素瘤的手術治療觀念也發生了變化。1987年Davidson等報導32例外陰黑色素瘤和陰道黑色素瘤患者,無論是採取根治性手術或單純的外陰切除術或單純局部切除術或是否輔助於放射治療,其治療效果都沒有顯示出差異。作者採用的根治性手術包括單純根治性外陰切除術、根治性外陰切除術加腹股溝淋巴結切除術或前盆腔除髒術。因此作者建議採取局部切除術,若腹股溝淋巴結有轉移的臨床證據,則加上腹股溝淋巴結的切除。對於外陰的巨塊病灶或廣泛局部復發者應考慮行根治性手術。隨後又有多箇中心臨床研究也沒有證實廣泛性手術優於切緣2cm的局部切除術。Verschraegen和他的同事在2001年總結了他們在1970~1997年收治的51例外陰黑色素瘤的治療情況,結果發現手術技術本身並沒有改變患者的預後。
(2)手術切緣:手術切緣是否徹底與疾病的復發和患者的預後有著顯著的關係。Rose等發現6例行保守性手術治療,切緣<2cm,其中3例復發,而6例切緣>2cm的患者僅1例復發。Trimble和他的同事總結了80例外陰黑色素瘤患者的治療效果發現,與不完全根治手術相比根治性手術似乎並不能提高患者的預後,建議對於ChungⅡ級浸潤深度≤1mm的薄病變行切緣1~2cm局部根治性切除,ChungⅢ級和Ⅳ級的厚病變切緣要求3cm,chungⅠ級行單純切除和密切隨訪即可。為預防復發即便是<0.76mm深的病變也應有足夠的切緣。有的作者提議實施一個具有3cm手術切緣的局部切除術即可達到所有外陰黑色素瘤的患者的治療效果。國內臧榮余報導15例外陰黑色素瘤治療經驗,他們建議早期(AJCCI期、Ⅱ期)可行單純外陰腫瘤廣泛切除術,切緣距腫瘤邊緣3cm以上,晚期強調綜合治療,擴大手術並不能改善預後。
基於以上的研究,厚度<1mm的外陰黑色素瘤切除1cm的正常皮膚切緣,厚1~4mm的腫瘤,切除2cm的皮膚切緣,被一些學者認為是一種合理處理對策。
(3)區域淋巴結的處理:GOG分析了71例外陰黑色素瘤的患者,發現FIGO分期、腫瘤大小和腫瘤的位置、毛細血管-淋巴管的受累和Breslow的腫瘤浸潤深度等與淋巴結的轉移有顯著關係,而淋巴結的轉移意味著患者的預後極差。從大規模的皮膚黑色素瘤研究中發現皮膚病灶深度<0.76mm者淋巴結轉移危險性十分低,將不能從淋巴結切除術中獲得益處,而病灶浸潤深度>4.0mm者將有十分高的淋巴結轉移和復發危險性,同樣也幾乎不能從淋巴結切除術中獲得益處。對於原發病灶深度為0.76~4.0mm的患者可能從選擇性淋巴結切除術中受益。並不是對所有的外陰黑色素瘤患者均行選擇性的淋巴結切除,Chung認為ChungⅡ級(腫瘤厚度≤1mm)不必行淋巴結切除術。Trimple等建議病灶厚度>0.76mm(ClarkⅢ級)的患者行預防性的淋巴結切除術,因為淋巴結陽性的患者可獲得長期存活。對於淋巴結微轉移的患者預防性淋巴結切除和外陰根治術可使患者10年生存率達31%。來自Phillips等的一份前瞻性有關外陰黑色素瘤淋巴結切除術及切除術類型的治療研究,與未行淋巴結切除者比較,陽性的淋巴結切除或陰性的淋巴結切除術都未能顯示出淋巴結切除術治療的優點。綜上所述對於浸潤深度>0.76mm(ClarkⅢ級)的外陰黑色素瘤患者,側旁病灶者應考慮行同側的淋巴結切除術,中心病灶者行雙側淋巴結切除術。去除臨床受累的淋巴結總是有益於外陰黑色素瘤患者。
3.化療和放療 既往認為黑色素瘤對化療和放療耐受,但近些年來的資料顯示晚期患者對化療和放療有效,對晚期患者單採用放療和化療使個別患者生存達10年以上。常用的化療藥物為達卡巴嗪(氮烯咪胺)、洛莫司汀(氯乙環己亞硝脲)、順鉑(DDP)、硫酸長春鹼(長春花鹼)、長春新鹼(VCR)等。治療黑色素瘤最有效的化療藥物為達卡巴嗪(DTIC),反應率為15%~25%,僅1%~2%的接受達卡巴嗪(DTIC)治療的患者獲得長期完全緩解。常用DVP方案(達卡巴嗪、長春新鹼、順鉑)、CPD(洛莫司汀、丙卡巴肼、放線菌素D)方案、BDPT(卡莫司汀、達卡巴嗪、順鉑、他莫昔芬)及VCD方案。
BDPT方案:
卡莫司汀(BCNU):150mg/㎡ 靜脈滴注第1天,每6~8周1次。
達卡巴嗪(DTIC):200~220mg/㎡靜脈滴注第1~3天,每3~4周1次。
順鉑(DDP):25mg/㎡靜脈滴注第1~3天,每3~4周1次。
他莫昔芬:10mg,2次/d,口服。6~8周為1個療程。
順鉑(DDP):20mg/㎡靜脈滴注第1~4天。
硫酸長春鹼(VLB):1.5mg/㎡靜脈滴注第1~4天。
達卡巴嗪(DTIC):200mg/㎡靜脈滴注第1~4天,或800mg/㎡,靜脈滴注,第1天。
3~4周為1個療程。
外陰局部和腹股溝區可採用體外照射,腫瘤累及陰道或陰道復發可採用陰道後裝治療。放療劑量為4000cGY~5000cGY,對高危患者主要是提高局部控制。對於遠處的腦、骨及內臟的轉移也可採用放療,起到緩解治療作用。不管是常規套用或作為緩解治療手段,放療僅可以緩解晚期患者的外陰黑色素瘤症狀,仍不能達到痊癒該病。
4.免疫治療
(1)干擾素α:ECOGG (Eastern CooperativeOncology Group)評價280個患ⅡB期或Ⅲ期或有區域淋巴結轉移的黑色素瘤病人,137例為對照,143例採用干擾素治療,用法:干擾素20MU/(㎡·d),靜脈給藥,每周5次,連用4周,後改為10MU/(㎡·d),皮下注射,每周3次,共48周。結果:用藥組無復發生存期和總生存期顯著延長,干擾素治療的受益者是那些淋巴結受累的患者。EC0G進一步的深入研究發現,高劑量的干擾素對那些具有高危黑色素瘤術後患者可顯著延長無瘤生存期和總生存期。這種效果是其他任何藥物、細胞因子及其他形式的疫苗不可比擬的。
(2)疫苗:黑色素瘤是最易產生免疫原性的腫瘤,因此黑色素瘤被作為腫瘤疫苗治療研究的主要模式。黑色素瘤患者血清中的IgM和IgG兩種球蛋白對自體及異體黑色素瘤能起異性反應,大約1/3的患者合併有腫瘤結節內淋巴結集中的現象。凍乾卡介苗(BCG,結核菌素)有增強網狀內皮系統吞噬力的作用,可採用凍乾卡介苗(BCG)皮膚劃痕法,每次75~150mg,面積7cm×8cm。國內報導15例生殖道黑色素瘤治療效果,發現生存超過1年者均採用手術、化療和凍乾卡介苗(BCG)的免疫治療,效果較好。隨著分子生物學技術的發展,一些編譯特異性的黑色素瘤抗原的基因被克隆,特異性抗原多肽分子被確定,利用特異性抗原可刺激機體產生特異性的主動免疫反應原理,已開發出新型特異性強的抗黑色素瘤疫苗。1998年,Piura報導1例25歲患ClarkⅣ級的原發性外陰黑色素瘤的患者,術後用異源性的特異性抗黑色素瘤疫苗輔助治療,獲得長期緩解,生存超過5年,開創了外陰黑色素瘤主動免疫治療的先河。
(3)阿地白介素(白介素-2):目前有關單獨白介素的治療劑量、用藥時間還沒達成一致。白介素與化療和(或)干擾素聯合套用的治療方案雖然達到較高的緩解反應率,但不能達到較好的長期存活。
(4)CLS細胞療法:目前,外陰黑色素瘤還沒有更好的治療方法,專家認為目前可採用第四大腫瘤生物治療技術即cls細胞療法與放化療進行配合治療。CLS細胞療法是一種新興的、具有顯著療效的腫瘤治療模式,是一種自身免疫抗癌的新型治療方法。它是運用生物技術和生物製劑對從病人體內採集的免疫細胞進行體外培養和擴增後回輸到病人體內的方法,來激發,增強機體自身免疫功能,從而達到治療腫瘤的目的。是目前國內實驗技術成熟,,臨床療效顯著,毒副作用小,患者易於接受,適用於各類、不同期腫瘤治療的重要生物治療方法。
1、腫瘤手術、放療或化療完成後套用,可恢復及加強其免疫抗腫瘤作用,消滅體內殘留癌細胞,減少腫瘤的復發和轉移,提高治癒率。
2、腫瘤放療、化療療程之間及結束後套用,可增強放療、化療療效提高對化療、放療的耐受性並減輕其副作用。
3、臨床治癒患者,定期套用,可以預防轉移和復發。
CLS自體免疫細胞治療技術不但可有效的消除外陰黑色素瘤化療這些毒副反應,恢復及加強其免疫抗腫瘤作用,而且還可以徹底消滅體內殘留癌細胞,減少腫瘤的復發和轉移,提高治癒率。相信隨著對外陰黑色素瘤研究的深入,診斷水平的不斷進步,治療手段的不斷發展,外陰黑色素瘤的生存率及生活質量會得到進一步提高。
術後護理
一、飲食護理:術後1~2天予進食高蛋白、高維生素等營養豐富的流質、半流質食物,避免進食硬的食物,減少咀嚼肌運動,以免加重眼部傷口疼痛或影響傷口癒合,術後3天后可多食纖維素含量高的蔬菜如芹菜、韭菜等,多食水果,以促進腸蠕動,防止便秘。
二、敷料的觀察護理:術後予繃帶加壓包紮4~5天,以達到眼球制動,預防切口裂開、眼內出血,要保持繃帶固定良好及眼部敷料清潔乾燥,如繃帶鬆脫、敷料滲濕應及時更換。
三、疼痛的觀察護理:術後因手術創傷,早期可有眼瞼腫脹、結膜水腫、患眼疼痛及偶見噁心、嘔吐等症狀,向患者及家屬做好解釋工作,注意觀察術後眼痛發生的時間、性質,評估疼痛是由於術中牽拉眼外肌、角膜上皮損傷、縫線觸及角膜引起還是由於繃帶加壓包紮造成的不適,根據疼痛的原因及時調整繃帶或套用止痛藥物緩解疼痛。如術後3天后眼痛加劇,要警惕眼內出血等併發症的發生,應及時報告醫生及時處理。
四、健康教育:手術後定期行放療、化療以及生物治療仍是降低復發率及轉移率的必要措施。告知患者術後放療、化療以及生物治療的必要性,並指導患者回院進行放療、化療或免疫治療的具體時間,並留下聯繫電話或地址。指導患者合理飲食,宜進高蛋白、高碳水化合物、高維生素、清淡、易消化的食物,加強營養,積極鍛練身體,增強體質,提高抵抗力,有利於疾病的康復。
五、併發症的觀察護理:眼內出血及繼發性視網膜脫離是最主要的併發症。①密切了解患者有無眼前紅色影子漂動、視力下降等情況,如出現上述玻璃體出血症狀時,應立即給予患者取半坐臥位,使視網膜下血液由於重力作用向下方積聚,防止黃斑區視網膜前膜形成並改善視野範圍,並囑患者減少眼球轉動,防止視網膜下活動性出血,並注意血壓的變化。按醫囑套用中西醫藥物予止血、活血化瘀治療。②如出現眼前固定黑影、閃光、視力急劇下降,應警惕繼發性視網膜脫離的發生。囑患者除進食、上廁所及必要的檢查外應多臥床休息,注意術眼的保護,勿晃動頭部、揉碰術眼,協助患者作好各項生活護理。
六、出院指導及隨訪:指導患者出院1周后回院複查,進行視力、眼壓、眼底等檢查,定期眼部、腹部B超檢查,判斷腫瘤有無復發、轉移。囑患者注意術眼衛生,勿碰撞術眼,1年內避免劇烈運動及重體力勞動,出現視力下降、眼前閃光、黑影要立即到醫院就診。術後隨訪至少不短於5年,最好能做到終身隨訪,並建立隨訪檔案,通過電話、通信等方法做到定期隨訪,儘可能詳細了解患者情況,解決存在問題,提高其生存質量。
醫學疾病任務——婦科
| 婦科是醫療機構的一個診療科目,是婦產科的一個分支專業,是以診療女性婦科病為診療的專業科室。女性生殖系統所患的疾病才叫婦科疾病。婦科疾病的種類可分很多種,本任務包含大多數婦科疾病。 |